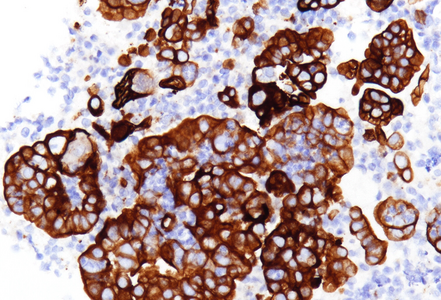

-
Die Universität
- Herzlich willkommen
- Das sind wir
- Medien & PR
-
Studium
- Allgemein
- Studienangebot
- Campusleben
-
Forschung
- Profil
- Infrastruktur
- Kooperationen
- Services
-
Karriere
- Arbeitgeberin Med Uni Graz
- Potenziale
- Arbeitsumfeld
- Offene Stellen
-
Diagnostik
- Patient*innen
- Zuweiser*innen
- Gesundheitsthemen
- Gesundheitsinfrastruktur
Case of the Month
October 2025
Ultrasound-guided biopsy of a pancreatic lesion in a 38-yeard-old woman (histological and cytological correlation).
Diagnosis
Poorly differentiated pancreatic adenocarcinoma with tumor-infiltrating neutrophils.
Comment
A 38-year-old female patient presented with a well-demarcated, homogeneous, hyperechoic lesion measuring 3,9x2,9cm, located in the head and body of the pancreas, accompanied by multiple enlarged lymph nodes. Ultrasound-guided endoscopic transgastric biopsies were performed on both the pancreatic lesion and the suspicious lymph nodes, as well as fine-needle cytological aspirations of the tumor.
Histological examination of the biopsy specimens revealed multiple small tissue fragments of a poorly differentiated adenocarcinoma, composed of markedly atypical epithelial cells arranged predominantly in disorganized, irregularly contoured glandular and duct-like structures. A distinctive feature observed was the prominent neutrophilic infiltration within the neoplastic glands, with neutrophils present both intraluminally and interspersed among the neoplastic epithelial cells (Panels A and B). The neoplastic cells displayed enlarged, pleomorphic, and hyperchromatic nuclei, with prominent nucleoli and high nuclear-to-cytoplasmic ratio, similar features were also observed in the cytologic smears (Panels C and D).
Upon immunohistochemistry, the tumor cells were positive for CK7 (Panel E) and MUC1 (Panel F). The Ki-67 proliferation index was markedly high (>90%; Panel G), and p53 showed an aberrant expression with strong diffuse positivity (Panel H).
The presence of neutrophils in tissue specimens presents a well-recognized diagnostic challenge, particularly when differentiating between reactive or inflammatory processes and neoplastic lesions. In reactive settings, intense neutrophilic inflammation can lead to epithelial changes, including nuclear atypia and increased mitotic activity. These findings can closely resemble neoplasia, both cytologically and architecturally, potentially leading to overdiagnosis.
On the other side, the interplay between inflammation and carcinogenesis is increasingly understood, with neutrophils and lymphocytes representing key components of the tumor microenvironment in various malignancies. In pancreatic ductal adenocarcinoma (PDAC), tumor-associated neutrophils (TANs) have gained attention, especially in histologic subtypes with aggressive behavior, such as micropapillary and undifferentiated carcinomas. Studies have reported that up to 5% of PDACs exhibit prominent intra- and peritumoral neutrophilic infiltrates — an uncommon feature in conventional ductal adenocarcinoma. These neutrophil-rich tumors often express MUC1 on their cell surface, which may act as a chemoattractant, contributing to neutrophil recruitment and retention within the tumor microenvironment.
Distinguishing TAN-rich PDAC from inflammatory or reactive lesions can be difficult, since dense neutrophilic infiltrates may mimic acute pancreatitis or other benign conditions. Conversely, inflammation-induced reactive atypia might be mistaken for dysplasia or malignancy.
To minimize diagnostic pitfalls, a comprehensive and integrative diagnostic approach is essential. Histopathological evaluation should assess not only the distribution of neutrophils (stromal vs intraepithelial), but also architectural distortion, cytological atypia, necrosis and the presence of desmoplastic stroma. Immunohistochemistry can provide valuable support, particularly with epithelial markers such as cytokeratins, MUC1, p53, and SMAD4, which may help distinguish neoplastic from reactive glands. Molecular studies — such as KRAS and TP53 mutation analysis — and proliferation markers like Ki-67 may further clarify difficult cases. Additionally, identification of a discrete mass, signs of invasiveness on imaging, or elevated tumor markers such as CA19-9 supports the diagnosis of malignancy over a purely inflammatory process.
For further reading
- Reid MD, Basturk O, Thirabanjasak D, Hruban RH, Klimstra DS, Bagci P, Altinel D, Adsay V. Tumor-infiltrating neutrophils in pancreatic neoplasia. Mod Pathol. 2011 Dec;24(12):1612–9
- Jin L, Kim HS, Shi J. Neutrophil in the pancreatic tumor microenvironment. Biomolecules. 2021;11(8):1170
- Pateras IS, Igea A, Nikas IP, Leventakou D, Koufopoulos NI, Ieronimaki AI, Bergonzini A, Ryu HS, Chatzigeorgiou A, Frisan T, Kittas C, Panayiotidis IG. Diagnostic challenges during inflammation and cancer: current biomarkers and future perspectives in navigating through the minefield of reactive versus dysplastic and cancerous lesions in the digestive system. Int J Mol Sci. 2024;25(2):1251
Presented by
Dr. Julia Azevedo, Porto, Portugal, and Dr. Cord Langner, Graz, Austria.